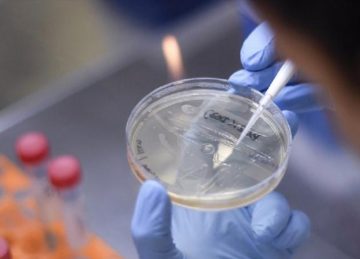

S-a modificat algoritmul de testare la nivel național pentru despistarea noului tip de coronavirus.
Ministerul Sănătății va considera prioritate de testare noi categorii de pacienții cu risc mare:
“Până în acest moment am luat o serie de măsuri restrictive cu scopul de a limita transmiterea infecției și de a reduce numărul de forme severe și decese. Sunt măsuri pe care le menținem în continuare, mă refer aici la distanțare socială, izolare, carantină etc. Dar, având în vedere evoluția numărului de decese este necesar să aplicăm, suplimentar, și măsuri de detecție a infecției la categorii de bolnavi care pot să dezvolte forme severe de îmbolnăvire, în scopul de a interveni cu tratament medical cât mai precoce”, a declarat ministrul Sănătății, Nelu Tătaru.
Astfel, s-a aprobat testarea, suplimentar, pentru:
– Pacienți înainte de procedura de transplant (asimptomatici) și donatorii de organe, țesuturi și celule stem hematopoietice înainte de donare; pacienți cu transplant de celule stem hematopoietice aflați în tratament imunosupresor, înaintea fiecărei internări din perioada de monitorizare post-transplant — 2 teste la 24 de ore interval
– Pacienți asimptomatici cu imunosupresie în contextul bolii sau indusă medicamentos la internare in spital — 2 teste la 24 de ore interval,
–Pacienți oncologici asimptomatici aflați in curs de chimioterapie — de 2 ori pe lună,
–Pacienți oncologici asimptomatici înainte de intervenții operatorii sau manevre invazive,
–Hemodializați simptomatici,
–Hemodializați asimptomatici contacți cu caz confirmat, 2 testări, la 6-7 zile interval intre ele; pe durata acestei perioade aceștia vor fi dializați in sesiuni separate de restul pacientilor,
–Gravidele asimptomatice care se află în carantină/izolare la domiciliu sau au fost contact apropiat cu un caz confirmat,
–Personalul de îngrijire din cămine de bătrâni — de 2 ori pe lună.
De asemenea, s-a hotărât că, unitățile sanitare pot stabili protocoale de testare prin tehnici de RT-PCR, suplimentar, pentru personalul sanitar asimptomatic contact direct cu caz confirmat, în a 6-7 zi de la ultimul contact posibil infectant, care pot fi realizate cu resurse proprii în laboratoarele pe care le dețin sau în alte laboratoare.









